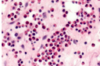

KOLOKWIA 2020/21 Flashcards
(63 cards)
Regeneracja endometrium po miesiączce jest przykładem:
- przerostu fizjologicznego
- rozrostu fizjologicznego
- rozrostu patologicznego
- metaplazji
- rozrostu fizjologicznego
Drobne (o średnicy 1-2mm) krwotoki do skóry, błony śluzowej lub surowiczej to:
- krwotok
- wybroczyny
- plamica
- wylewy krwawe
- wybroczyny
Przedstawiony obraz jest typowy dla:
- ostrego zastoju płucnego
- przewlekłego zastoju płucnego
- obrzęku płuc
- zapalenie śródmiąższowe płuc

- przewlekłego zastoju płucnego
Zwyrodnienie kropelkowo-szkliste dotyczy najczęściej:
- nerek
- wątroby
- mózgu
- serca
Zachowany zarys tkanki, mimo martwicy budujących ją komórek jest charakterystyczny dla martwicy:
- włóknikowatej
- serowatej
- skrzepowej
- rozpływnej
3.skrzepowej
Nie jest elementem triady Virchowa:
- zastój lub turbulentny przepływ
- nadkrzepliwość krwi
- zwiększona osmotyczność osocza
- uszkodzenie śródbłonka
zwiększona osmotyczność osocza
W zakażeniach bakteryjnych i grzybiczych możemy obserwować zazwyczaj martwicę:
skrzepową
rozpływną
serowatą
włóknikowatą
rozpływną
Zmiany przedstawione na zdjęciu są wynikiem:
zawału bladego nerki
zawału czerwonego nerki
zawału bladego serca
zawału czerwonego serca

zawału bladego nerki
Po wystąpieniu krwawienia możemy się spodziewać w makrofagach obecności:
melaniny
lipofuscyny
hemosyderyny
glikogenu
hemosyderyny
Po jakim czasie od wystąpienia niedokrwienia następuje śmierć kardiomiocytów:
1-2 minutach
20-30 minutach
2-3 godzinach
6-12 godzinach
20-30 minutach
Wskaż nieprawdziwe określenie dotyczące tętniaków prawdziwych:
są ograniczone wszystkimi trzema warstwami ściany tętnicy
mogą być wrodzone
mogą powstać na podłożu miażdżycy
powstają z krwiaka pozanaczyniowego
powstają z krwiaka pozanaczyniowego
Zawał czerwony z największym prawdopodobieństwem wystąpi w:.
płucu
nerce
śledzionie
sercu
płucu
Rodzaj techniki polegającej na poszukiwaniu określonych antygenów na komórkach lub w tkankach z wykorzystaniem przeciwciał oraz reakcji barwnej, to badanie:
śródoperacyjne
cytologiczne
immunohistochemiczne
cytometryczne
immunohistochemiczne
Białkowo-lipidowa substancja obecna w komórkach mięśnia sercowego na przedstawionym preparacie to:
hemosyderyna
pył węglowy
glikogen
lipofuscyna

lipofuscyna
Szlak ubikwitynowo-proteasomowy bierze udział w:
rozkładzie białek zewnątrzkomórkowych
rozkładzie białek wewnątrzkomórkowych
syntezie białek wewnątrzkomórkowych
syntezie białek wewnątrzkomórkowych xD
rozkładzie białek wewnątrzkomórkowych
Cechą wskazującą na wystąpienie martwicy, a nie apoptozy jest:
obkurczenie komórki
towarzyszące zapalenie
uszkodzenie pojedynczych komórek
zachowanie błony komórkowej
towarzyszące zapalenie
Występuje jako kwasochłonny wtręt cytoplazmatyczny w komórce plazmatycznej:
ciałko Russella
ciałko Mallory’ego
ciałko Langerhansa
ciałko tłuszczowe
ciałko Russella
Widoczny na zdjęciu obszar to:
martwica
apoptoza
zanik
metaplazja
martwica
Masy fosfolipidów powstające z uszkodzonych błon komórkowych obecne w cytoplazmie uszkodzonych komórek to:
ciałka apoptotyczne
ciałka Mallory’ego
ciałka Russella
figury mielinowe
figury mielinowe
Karioreksja to:
upłynnienie jądra komórkowego
obkurczenie jądra komórkowego
fragmentacja jądra komórkowego
powiększenie jądra komórkowego\
fragmentacja jądra komórkowego
Widoczne na zdjęciu zmiany w wątrobie są związane z gromadzeniem w hepatocytach:
białek
wapnia
lipofuscyny
lipidów

Martwica włóknikowata występuje typowo w obrębie:
chrząstki
naczyń
nabłonków
nerwów
naczyń
Zmianą świadczącą o nieodwracalnym uszkodzeniu komórki jest:
pojawienie się figur mielinowych
obrzęk retikulum endoplazmatycznego
uszkodzenie mitochondriów z zaprzestaniem produkcji ATP
wybrzuszenia błony komórkowej
uszkodzenie mitochondriów z zaprzestaniem produkcji ATP
Do czynników predysponujących do rozwoju zakrzepicy należą wszystkie wymienione za wyjątkiem:
zawału mięśnia sercowego
choroby nowotworowej
stosowania doustnych środków antykoncepcyjnych
zmniejszenia stężenia czynnika VIII lub fibrynogenu
zmniejszenia stężenia czynnika VIII lub fibrynogenu